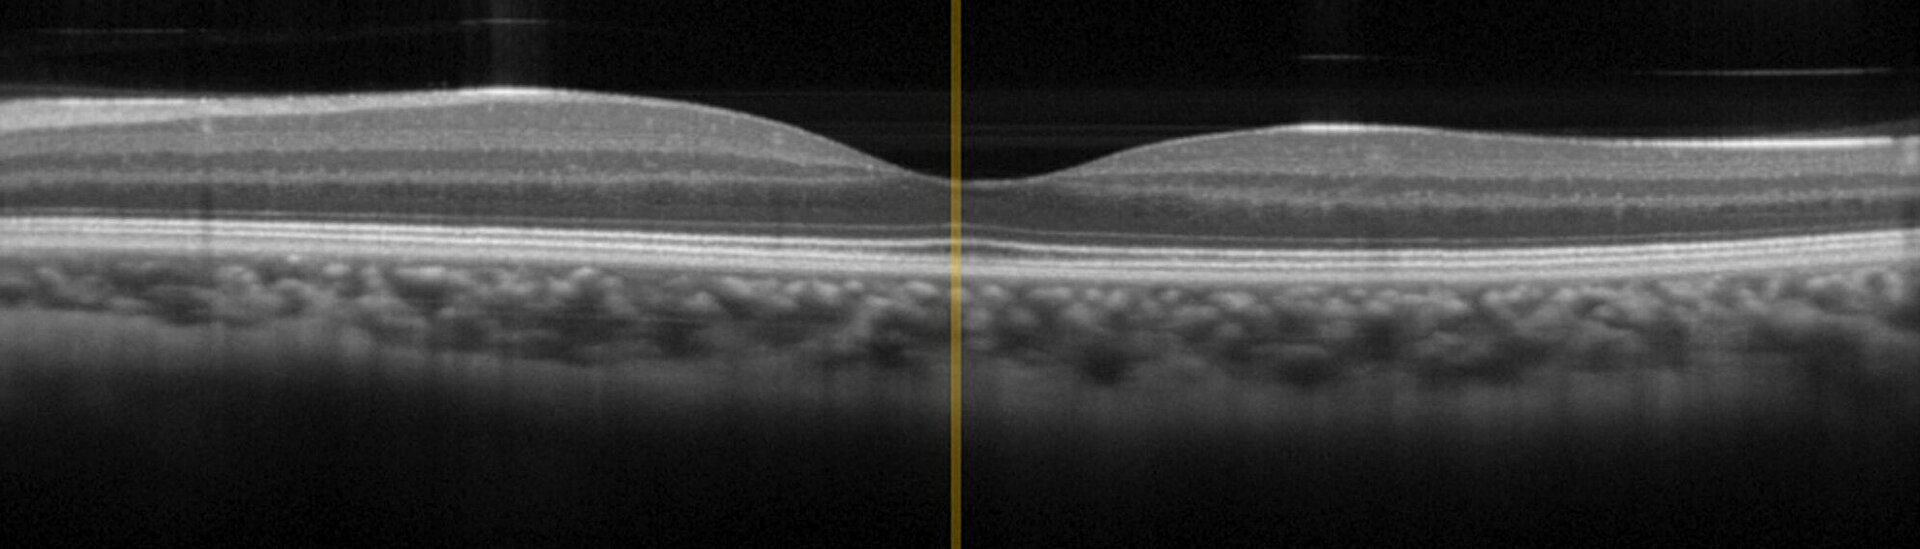
Physik Instrumente OCT Test Image

Scanning Stages for Fast and Reliable Image Acquisition in OCT Devices for Ophthalmology and Dermatology
OCT is an interferometric imaging technique based on broadband infrared light in the wavelength range between 0.8 µm and 1.4 µm for optimal tissue penetration. OCT has already achieved "Gold Standard" in ophthalmology but recently also finds growing application in dermatology, for example to diagnose skin cancer. In comparison to conventional invasive diagnostic measures, OCT delivers results faster and reduces side-effects and stress on patients.
Michelson Interferometer Setup for Tissue Examination
The OCT technology uses broadband IR light (in the wavelength region between 800 - 1400 nm due to best penetration in tissue) with short coherence lenght in a Michelson interferometer setup. The signal is a result of the interference from probe- and reference-beam, based on reflections at refractive index boundaries within biological tissue.
Thus, OCT technique relies on the precise and dynamic axial scanning of an optical beam ((1) - see drawing) in one of the interferometer arms. For this purpose, PI offers nanopositioning stages that help to provide maximum image resolution. Based on different drive technologies and standard products, PI can adapt the scan axis to device- and application-specific requirements: Size, travel range (stroke), drive type (voice coil or piezo drive), and resolution can be specifically adapted to the overall design of the OCT device. Sophisticated controller technology and a variety of interfaces allow easy access to the stage.
Typical Specifications
The most relevant specification for axial scanning is the penetration depth (z) which typically is in the range of 0.4 mm - 3 mm. This value directly defines the minimum required travel range of the stage. Further specifications comprise:
- Axial resolution: 0.5 - 15 µm (half of coherence lenght!)
- Lateral resolution: 1.3 - 3 µm (light focus diameter)
- Scan rate: 85 - 1500 kHz (depending on technology)
- Image 2D/3D frame rates: 10 - 30 fps
Precision Motion Systems for Scanning
Several drive concepts can be used for to satisfy the requirements of modern OCT systems.
Piezoelectric Flexure-Guided Nanopositioning Scanners
Several piezo-driven motion principles are feasible. The two examples shown below are based on piezoelectric stack actuators driving a flexure-guided stage platform (right) and a microscope objective mount, respectively. Flexure-guided, piezoelectric linear nanopositioning stages provide the highest possible resolution and precision; in addition, they are both friction-free and wear-free and virtually require no power to hold a position.


Voice Coil Linear Motor-Driven Scanning Stages
Voice coil motors are based on the electromagnetic principle well-known from loudspeakers. They are best suited to motion ranges from ~0.5 mm to 25 mm (1 inch). Voice-coil motors are frictionless, wear-free, and can provide highly dynamic and precise motion, as every music lover can attest to. When used in scanning and positioning stages, they are often combined with crossed-roller rails to provide high precision guidance. Linear encoders integral to the scanning stages provide feedback to a closed-loop motion controller to allow for precise position and velocity control.


Customized Stages
Based on the technology of the standardized products shown above, there are many possibilities to develop customized solutions with respect to: